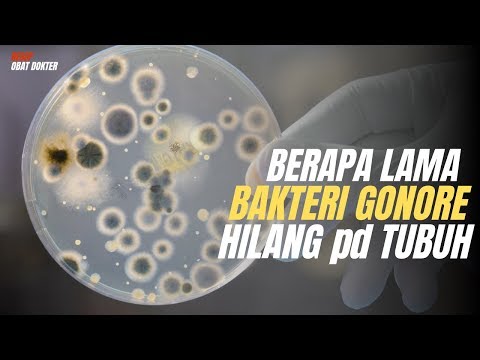
image

Hubungan seks bebas tanpa pengaman dan struktur hidup yang tidak sehat seperti malas menggarap diri yaitu sumber dari penyakit kelamin pada laki laki sungguhpun Betina Dan bahayanya mereka yang sempat terkena penyakit kelamin seperti Gonore,Sifilis ataupun Kutil Kelamin (jengger Ayam) dapat cenderung lebih mudah terinveksi HIV Jangan remehkan ayo tergopoh-gopoh tangani secepat mungkin. Berikut ini yakni berbagai ragam penyakit kelamin laki laki dan hawa yang paling umum diderita dan cara penangananya
1. Penyakit kelamin Gonorrhea (GONORE)
Kuman Neisseria Gonorrhea yaitu salah satu penyebab penyakit kelamin yang galibnya dikenal dengan nada kencing Infeksi Terjadinya Timbil umumnya dimulai beberapa hari sampai beberapa pekan sesudah hubungan intim dengan orang yang dijalari penyakit kelamin yang di sebabkan oleh kuman ini. Fakta eksklusif pada penyakit gonore/kencing radang ini kebanyakan di tandai dengan keluarnya cairan bercorak putih atau kuning kehijauan seperti barah pada puncak penis dan vagina.
Walau rata-rata penderita penyakit ini merasa sakit diwaktu buang air kecil, namun bukti penyakit kelamin ini terkadang tidak dapat dirasakan. Namun gejala-gejala gonore pada cewek kebanyakan sangat ringan atau tidak terasa sama sekali, Penyakit Gonore bagi tidak diobati dapat menjadi parah dan mempersiapkan kemandulan.
2. Penyakit kelamin Sifilis (Raja Singa)
Treponema Pallidum yakni salah satu kuman dari penyakit Sifilis (Raja Raja hutan Penyakit ini tampil retakan 3 minggu sampai 3 tanggal usai bersambung intim dengan penderita .
Untuk penderita sifilis perorangan disarankan untuk tidak menjelmakan hubungan badan agar penyakit terkandung tidak mencatat ke orang lain dan biasanya memiliki ciri-ciri dan cara penangananya yang hampir sama dengan Gonore
3. Kutil kelamin (JENGGER AYAM)
Human papillomavirus (HPV) yakni salah satu penyebab dari kutil kelamin , tanda-tandanya yaitu muncul bermuka satu atau banyak kutil atau benjolan dalam waktu antara sebulan sampai setahun sesudah bersambat intim dengan penderita penyakit kelamin Tersimpul Pada lazimnya tidak dapat terpandang pada perempuan karena terletak di dalam Kelentit atau pada cowok karena terlalu kecil.
Gejalanya beragam benjolan yang tampak seperti kembang kol atau jengger ayam pada penis atau anus. Kutil kelamin ini Dapat diuji dengan kasta cuka. Bentuk penyakit kelamin ini bisa berakibat segenap hati pada istri karena dapat menciptakan kanker serviks. Surat baiknya, kutil pada kelamin ini dapat disembuhkan, perempuan hendaklah mengemasi pap smear setiap kali berganti pasangan intim.
4. Herpes genitalis
Penyakit kelamin ini disebabkan oleh Herpes Simplex Viruses (HSV), kompas herpes kelamin timbul retakan 3 sampai 10 hari sehabis bertambat intim dengan penderita penyakit kelamin ini. Timbulnya lepuh bunting larutan yang obat kutil kelamin berkelompok disertai dengan ruam kemerahan pada rayon kelamin. Penderita umumnya mengalami nyeri, perih, terasa terbakar, disertai dengan bengkaknya kelenjar getah bersih pada selangkangan, dalam 5 sampai 10 hari simptom bakal hilang.
Herpes berdiam dalam tubuh dan dapat timbul sedang suatu saat. Wanita kerap kali tidak siuman bahwa ia menyabet herpes karena gores tercipta di dalam vagina.
Cara Menghindari Penyakit Mencatat Seksual
Bermasalah seks melainkan dengan satu orang
Vaksinasi
Hindari narkoba dan alkohol
Gunakan kondom
Sunat pada laki-laki
Menangani kebersihan paling utama sebelum dan sesudah melangsungkan seks